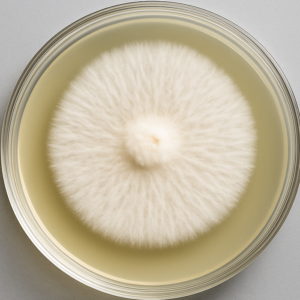
Stropharia rugoso-annulata Wine Cap Mushroom Culture
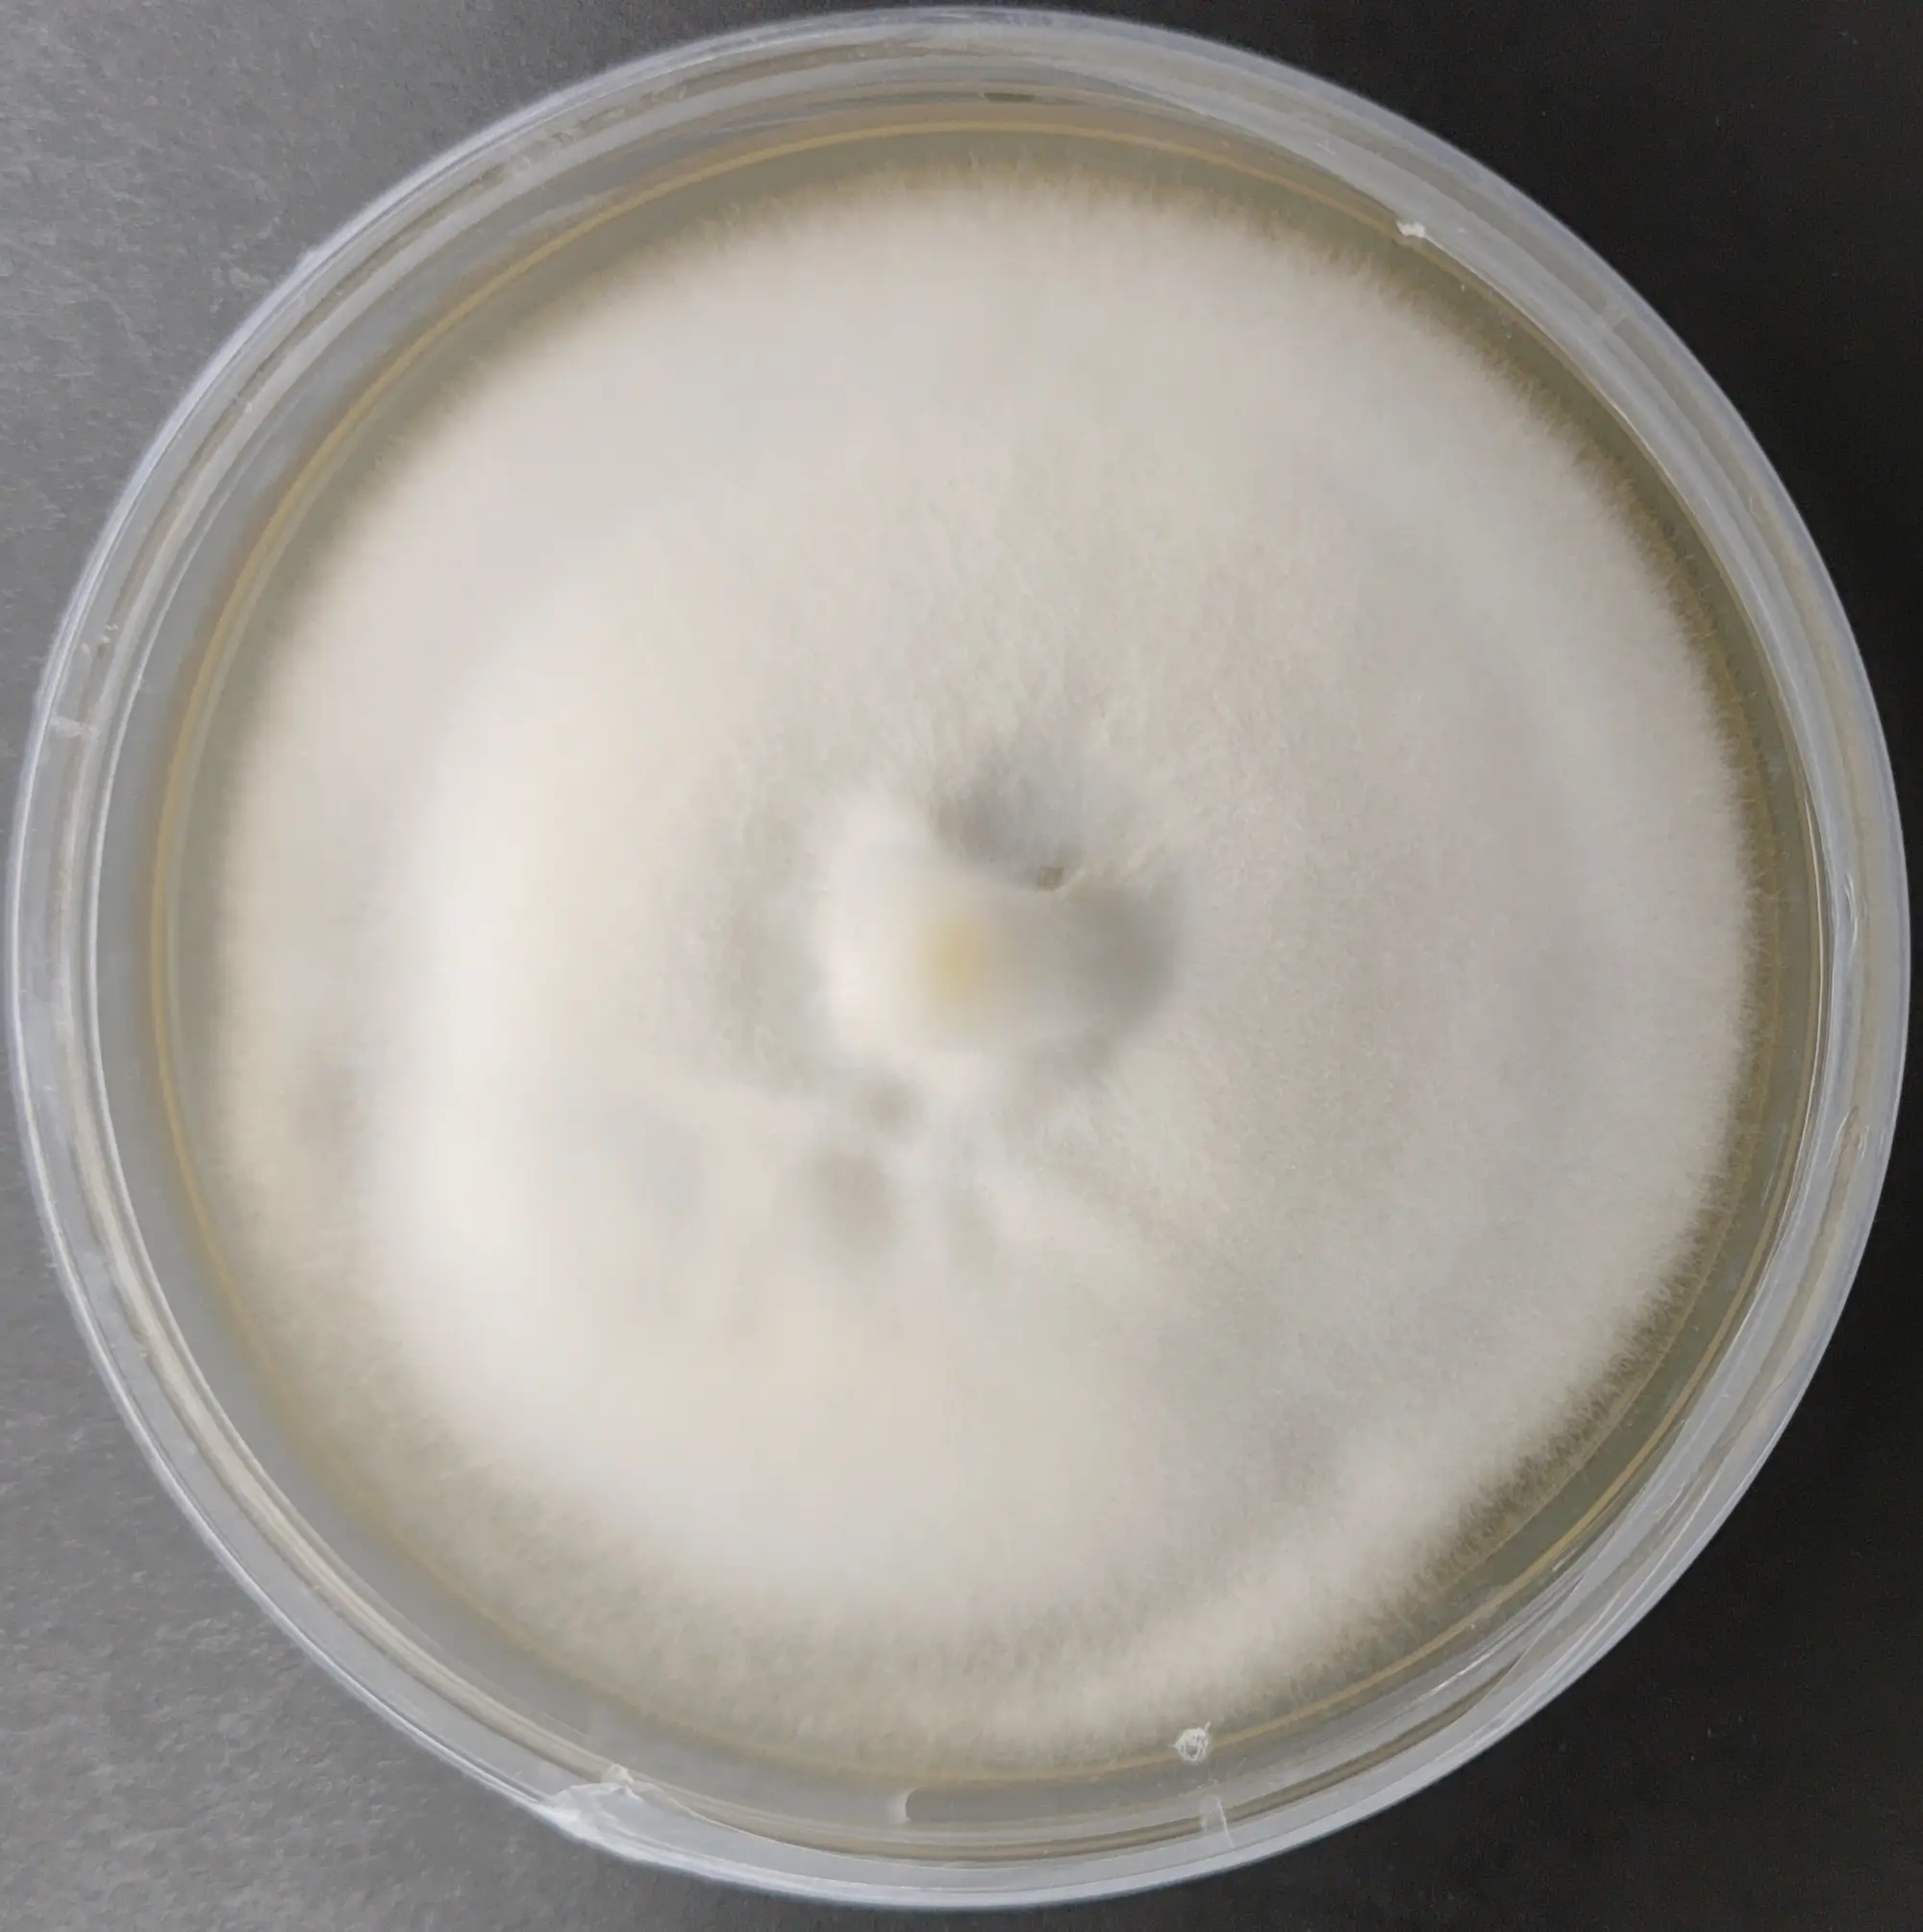
Tolypocladium ophioglossoides Goldenthread Cordyceps agar plate

PURE CULTURE of INDUSTRIAL FUNGUS
Ceriporus squamosus Dryad’s Saddle culture
MUHSROOM CULTURE BANK PURE CULTURE - INDUSTRIAL FUNGUS PURE CULTURE - SPECIALTY MUSHROOMS All Products
Fomes fomentarius Hoof Fungus Culture Plate
MUHSROOM CULTURE BANK PURE CULTURE - INDUSTRIAL FUNGUS PURE CULTURE - SPECIALTY MUSHROOMS All Products